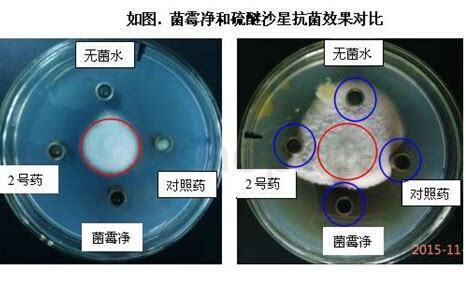

水霉病是一种常见的植物病害,常发生在高温高湿的环境中,严重影响着作物的产量和品质。针对这种病害,我们需要从多方面进行防治。
生物防治
生物防治是一种较为环保的防治方式,其基本原理是利用一些天敌或微生物来控制病害的发生。如利用一些有益菌株减少土壤中病原菌的数量,或者利用一些昆虫来捕食害虫等。在水霉病的防治中,可以利用一些具有生物防治效果的菌剂,如枯草芽孢杆菌、链格孢等,通过喷洒等方式来防治水霉病。
化学防治
化学防治是一种常见的防治方式,常用的化学药剂有三唑酮、多菌灵、氧乐果等。但是,化学防治也存在一些问题,如过多使用化学药剂容易导致药剂残留,对人体和环境造成危害。因此,在使用化学药剂时,要严格按照使用说明进行使用,避免过量使用,且要注意药剂残留的情况。
避免高温高湿环境
水霉病是一种高温高湿环境下易发生的病害,因此,避免作物在高温高湿的环境下生长是非常重要的。可以通过选择适合生长的品种、加强排水、保持良好的通风等措施来避免高温高湿环境的形成,从而减少水霉病的发生。
加强田间管理
加强田间管理也是防治水霉病的重要措施之一。包括及时清理田间积水、剪除病叶、及时清理病害残留物等。同时,也要注意作物的施肥、灌溉等管理措施,保持作物的健康生长状态,减少病害发生的机会。
水霉怎么养
治疗方法很简单在龟的日常饲养管理中,应经常让龟晒太阳,以抑制水霉菌滋生,达到预防效果。对已生病的龟可配制低浓度的食盐水浸泡,并用高锰酸钾溶液对饲养容器浸泡消毒。
同时,在投喂的饲料中,拌入适量的抗生素,提高龟的抵抗力,也可将龟饲养在1%的奇霉素溶液中一段时间,也有很好的效果。简单点说就是注意水质问题家养就直接用自来水就好,其他什么水都不要用自来水使用前必须静置2~3天或阳光直晒1天
总结
防治水霉病需要从多方面入手,选择合适的防治方式,并加强田间管理,避免高温高湿环境的形成,才能有效地控制水霉病的发生,保证作物的产量和品质。
赞同(72)